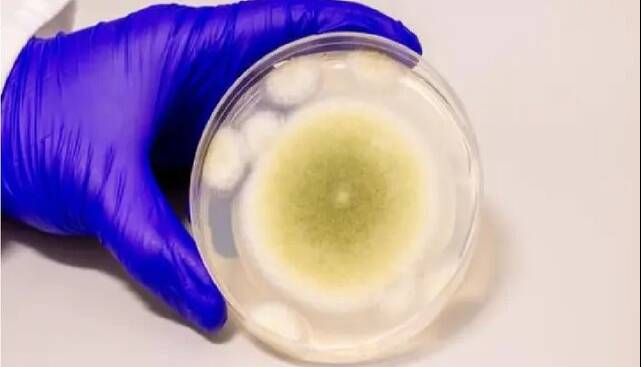

دوشنبه 05 اسفند 1404 - 02:35
استخراج داروی سرطان از قارچ مرگباری که جان ۱۰ دانشمند را گرفت
ایسنا/ از قارچ مرگباری که جان ۱۰ دانشمند را گرفته، اکنون دارویی قوی برای نابودی سرطان تولید شده است.
پژوهشگران موفق به استخراج دستهای جدید از مولکولها از قارچ مرگبار «Aspergillus flavus » شدهاند. آنها با استفاده از این قارچ کشنده به ترکیبی قدرتمند برای مبارزه با سرطان دست یافتهاند.
به نقل از آیای، اهمیت این کشف زمانی دوچندان میشود که بدانیم این قارچ سمی که در محصولات کشاورزی یافت میشود، پیشتر با مرگهای مرموز در حفاریهای باستانشناسی مرتبط بوده است.
برای مثال، در سال ۱۹۲۲، پس از گشوده شدن مقبره توتعنخآمون(یکی از فراعنه مصر)، مرگهای عجیب و غیر قابل توضیحی رخ داد که شایعاتی درباره «نفرین فرعون» را به وجود آورد، اما بعدها این فرضیه مطرح شد که شاید یک قارچ عامل این مرگها بوده است.
در دهه ۱۹۷۰ نیز در لهستان، حادثهای مشابه رخ داد. ۱۰ دانشمند ظرف چند هفته پس از ورود به مقبره «کازیمیر چهارم» جان خود را از دست دادند. عامل این مرگها قارچی به نام «Aspergillus flavus » تشخیص داده شد، قارچی که به سمی بودن شدید معروف است.
اسپورهای زرد این قارچ، حتی پس از هزاران سال میتوانند عفونتهای شدید ریوی ایجاد کنند، بهویژه برای کسانی که سیستم ایمنی ضعیفی دارند.
اکنون همین میکروب کشنده، به منبعی غیرمنتظره برای کشف داروی ضدسرطان تبدیل شده است.
گروهی از پژوهشگران به رهبری پروفسور شری گائو(Sherry Gao) از دانشگاه پنسیلوانیا موفق به استخراج دستهای جدید از مولکولها از این قارچ شدهاند.
شناسایی ترکیبات
کشف دارو از قارچها چیز تازهای نیست. قارچها مدتهاست منبعی ارزشمند برای تولید ترکیبات دارویی بودهاند.
مشهورترین نمونه آن، پنیسیلین است که در سال ۱۹۲۸ از قارچ «Penicillium notatum» بهدست آمد و انقلابی در درمان عفونتهای باکتریایی ایجاد کرد.
گائو میگوید: طبیعت داروخانهای شگفتانگیز به ما داده است. این وظیفه ماست که رازهای آن را کشف کنیم.
در این پروژه، تمرکز این تیم روی گروهی کمیاب از مولکولها به نام «پپتیدهای سنتز شده ریبوزومی و اصلاحشده پس از ترجمه»(RiPPs) بود. این مولکولها ابتدا توسط ریبوزومها ساخته میشوند و سپس برای افزایش فعالیت زیستیشان اصلاح شیمیایی میشوند.
اگرچه هزاران نوع RiPP در باکتریها شناسایی شدهاند، اما تنها تعداد انگشتشماری از آنها در قارچها یافت شدهاند. خالصسازی آنها بسیار دشوار است،
«کیویو نیه»(Qiuyue Nie) نویسنده ارشد این مقاله میگوید: سنتز این ترکیبات، بسیار پیچیده است، اما همین ویژگی است که به آنها فعالیت زیستی فوقالعادهای میبخشد.
محققان با بررسی دوازده گونه از قارچ Aspergillus و مقایسه تولیدات شیمیایی آنها با ساختارهای شناختهشده RiPP، رد این ترکیبات را در Aspergillus flavus یافتند.
اثرگذاری روی سلولهای لوسمی انسانی
پژوهشگران با تحلیل ژنتیکی توانستند منبع تولید این RiPPهای قارچی را شناسایی کنند و با کمال شگفتی، به دستهای کاملاً جدید از مولکولها با ساختار منحصربهفردی از حلقههای بههمپیوسته رسیدند. آنها این مولکولها را «آسپریجیمایسینها» (asperigimycins) نامگذاری کردند.
زمانی که این ترکیبات روی سلولهای لوسمی انسانی آزمایش شدند، دو مورد از چهار نوع آن حتی بدون اصلاح توانستند بهطور مؤثری سلولهای سرطانی را نابود کنند.
نقطه عطف واقعی اما زمانی رقم خورد که این ترکیبات کمی اصلاح شدند. پژوهشگران با افزودن یک مولکول چربی(لیپید) به این ترکیبات موفق شدند عملکرد آنها را با داروهای تأییدشدهای مانند «سیتارابین» و «داونوروبیسین» که سالهاست در درمان لوسمی کاربرد دارند، برابر کنند.
این اصلاح چگونه قدرت دارو را افزایش داد؟
پژوهشگران دریافتند که یک ژن کلیدی به نام SLC46A3 مانند دروازهای عمل میکند که اجازه میدهد آسپریجیمایسینها با تعداد بالا وارد سلولهای لوسمی شوند.
آزمایشهای بعدی نشان دادند که این ترکیبات چگونه عمل میکنند. آنها روند تقسیم سلولی را مختل میکنند.
گائو توضیح میدهد: سلولهای سرطانی بهطور کنترلنشده تقسیم میشوند. این ترکیبات با جلوگیری از تشکیل میکروتوبولها که برای تقسیم سلولی ضروری هستند، جلوی آن را میگیرند.
نکته جالب توجه این است که این ترکیبات اثر خاصی روی سلولهای دیگر مانند سلولهای سرطان پستان، کبد، ریه یا حتی انواع مختلف باکتریها و قارچها نداشتند. این اختصاصی بودن، ویژگی بسیار مهمی در طراحی داروهای جدید است.
افقهای تازه در پزشکی
کشف آسپریجیمایسینها دروازهای به دنیایی تازه در داروسازی باز کرده است. پژوهشگران همچنین ژنهای مشابهی در قارچهای دیگر شناسایی کردهاند که نشاندهنده گنجینهای پنهان از RiPPهای قارچی است.
«نیه» میگوید: اگرچه فقط چند مورد RiPP قارچی کشف شدهاند، اما تقریباً همه آنها فعالیت زیستی بالایی دارند. این منطقهای کشفنشده با پتانسیلی عظیم است.
گام بعدی، آزمایش آسپریجیمایسینها روی مدلهای حیوانی با هدف نهایی ورود به آزمایشهای بالینی انسانی است.
نتایج این مطالعه در مجله Nature Chemical Biology منتشر شده است.
پربیننده ترین
-
عکس مسی درآمد؛ آخرین توپ طلا با آرایشگر ویژه!
-
10 جایزه 5 میلیون تومانی برای کاربران آخرین خبر (مهلت شرکت در مسابقه تا 9 آذر تمدید شد.)
-
10 جایزه 5 میلیون تومانی برای کاربران آخرین خبر (مهلت شرکت در مسابقه تا 9 آذر تمدید شد.)
-
چراغ قوه همه کاره ( پاور بانک، شیشه شکن و ... )
-
هشدار آبفای کشور به مردم؛ هیچ ماموری فعلا برای قرائت کنتور آب مراجعه نمیکند
-
آخرین وضعیت راهها در چهارمین روز از سال جدید؛ محور چالوس از شنبه دوباره بسته میشود
-
جارو شارژی !! دیگه نگران نظافت ماشین نباشید
-
زنده؛ بیرانوند در یک قدمی استقلال
-
"دنا پلاس اتومات" بخریم یا "تارا اتومات؟"/ مقایسه اختصاصی "آخرینخودرو" از دو خودروی پرطرفدار
-
فشار آبرو چند برابر کن ....
-
فرمانده کل قوا: ملت ایران در مقابل جنگ تحمیلی محکم میایستد همانگونه که در مقابل صلح تحمیلی نیز محکم خواهد ایستاد
-
چالش/ بازیکن داخل تصویر رو حدس بزن (16)
-
5 نشانه ضعیف شدن ریه ها و بهترین روش تقویت آن چیست؟
-
لندکروزر یا ۲۰۶؟ / مقایسه جالب "آخرینخودرو" به بهانه سخنان جنجالی میرسلیم
-
پایان زودهنگام گنبد آهنین؟ اسرائیل مجبور به جیرهبندی موشکها شد
-
سپ، برترین شرکت در خاورمیانه شد
-
گردونه را بچرخانید، بیتکوین دریافت کنید
-
واکنش عراقچی به تجاوز امروز آمریکا به تأسیسات هستهای فردو، نطنز و اصفهان
آخرین اخبار
-
مکلارن تسلیم شد، ابرشاسیبلند هیبرید برای رقابت با فراری ساخته میشود
-
حریق خودروی پراید در الهیه جنوبی بندرعباس
-
10 رینگ معروف در صنعت خودرو؛ کدام یک انتخاب شماست؟
-
جریمه قاچاقچی حوله تنظیف در اندیمشک
-
معاون رئیسجمهور: بهرهبرداری ناپایدار تهدیدی برای محیطزیست چهارمحال وبختیاری است
-
فراری پوروسانگوئه G ادیشن کیوانی، دایناسور زرد ۱.۵ میلیون دلاری!
-
دیدار رئیس پارلمان عراق با کاردار آمریکا بر سر سرنوشت پایگاه عینالاسد
-
شوهرم در رسیدگی به بچهها ابدا کمک نمیکند
-
رونمایی از لوگو هیئت فوتبال استان تهران با حضور مهدی تاج
-
استانداری مازندران به پنل خورشیدی مجهز شد
-
رئیس کل گمرک: طلای وارداتی بابک زنجانی قاچاق نبوده است
-
تمدید کنسرت «ایرانم» علیرضا قربانی
-
بهروز سلطانی: وقتی از برخی ایجنت ها بازیکنی جذب پرسپولیس نمی شود
-
بهروز سلطانی: وحید هاشمیان مدیریتی در سطح علی پروین دارد، اگر به حاشیه نرود صد درصد موفق می شود
-
حضور مهدی تاج در مجمع سالیانه هیئت فوتبال تهران
سایر اخبار مرتبط
نظرات
ثبت نظر
مهمترین اخبار

رئیس کل گمرک: طلای وارداتی بابک زنجانی قاچاق نبوده است
سهشنبه 05 شهریور 1404 - 12:06:40

۸۶ درصد از مطالبات گندمکاران تسویه شد
سهشنبه 05 شهریور 1404 - 12:00:54

ورود گروه صنعتی زر به باشگاه کلان پروژههای انرژی خورشیدی
سهشنبه 05 شهریور 1404 - 11:59:40

افزایش مجدد قیمتها در بازار طلا و سکه؛ دلار به کانال 96 هزار تومان رسید
سهشنبه 05 شهریور 1404 - 11:38:45

واردات هفت کشتی بنزین در جنگ ۱۲ روزه به کشور
سهشنبه 05 شهریور 1404 - 11:27:00



